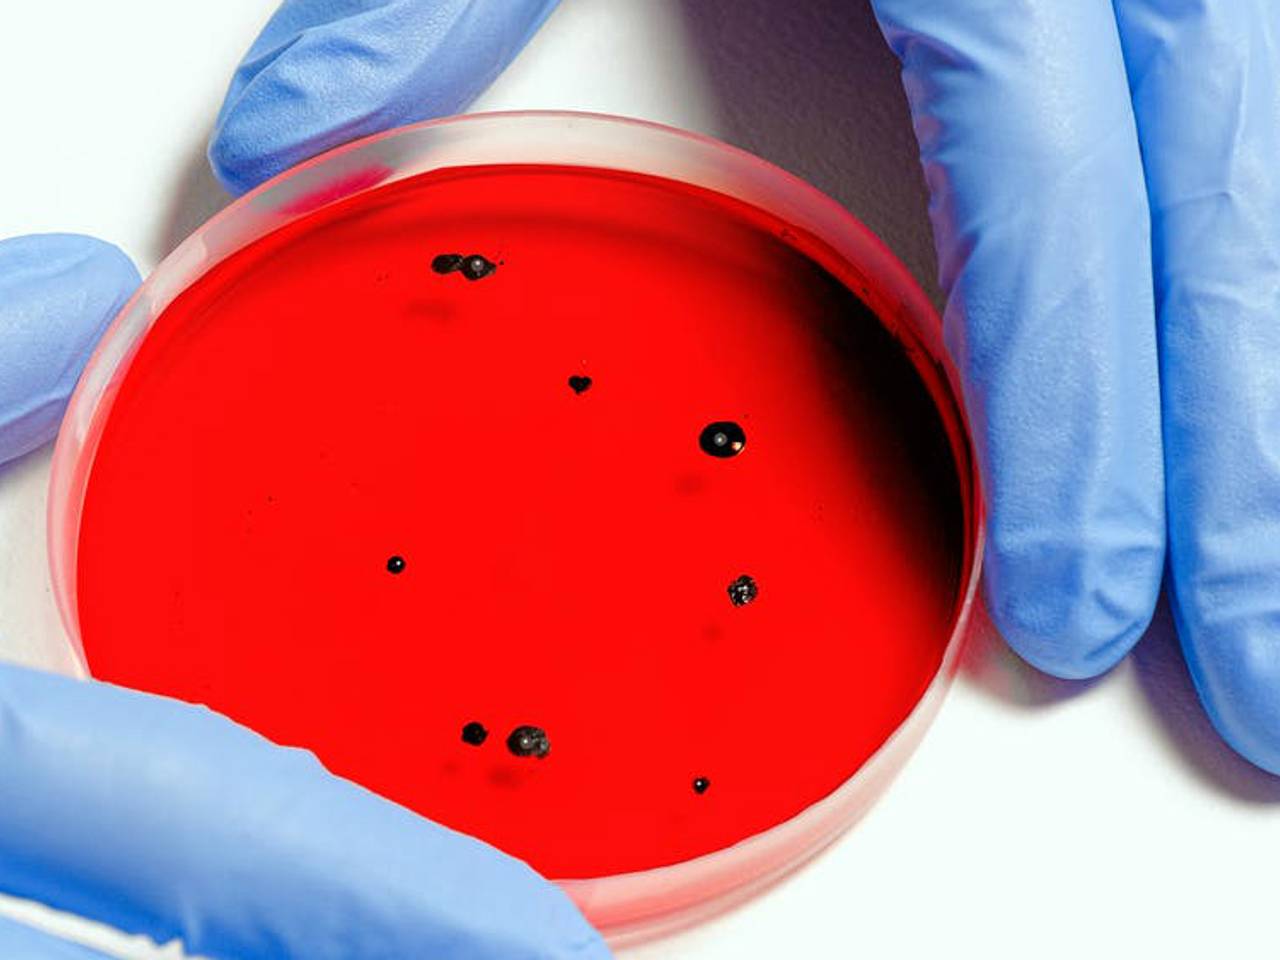
Omroep Brabant

Coronanieuws: Militairen kazerne Oirschot in thuisisolatie vanwege mogelijke coronabesmettingen
In dit liveblog houden we je donderdag op de hoogte van het laatste nieuws rond de coronacrisis.
De voornaamste feiten op een rij:
- In de afgelopen 24 uur zijn er 132 besmettingen bijgekomen in het hele land.
- In Brabant zijn er in totaal 9651 mensen besmet (geweest) met het virus.
- Brabanders hebben een stuk vaker antistoffen tegen het coronavirus in hun bloed dan inwoners van andere provincies.
- Landelijk gezien zijn er 4 sterfgevallen bijgekomen en 3 ziekenhuisopnames.
- De werkloosheid in Nederland is, mede als gevolg van de coronacrisis, opgelopen tot 3,6 procent van de beroepsbevolking.
- Door de coronacrisis gaan het komende anderhalf jaar bijna achtduizend bedrijven in Nederland failliet.
- Lees al het nieuws over het coronavirus op onze speciale themasite.
Dit liveblog is gesloten. Vanaf vrijdagochtend houden we je in een nieuw liveblog weer op de hoogte van al het nieuws rondom de coronacrisis.
22.23
Het wielercriterium van Boxmeer, Daags na de Tour genoemd, gaat niet door. Het criterium zou aanvankelijk, ook dit jaar, een dag na afloop van de Ronde van Frankrijk in september worden verreden. Beiden wielerkoersen waren verplaatst vanwege de coronacrisis. Het is voor het eerst in 45 jaar dat het criterium niet doorgaat.
21.43
In het Bredase Amphia Ziekenhuis is de laatste coronapatiënt van de intensive care af. Er zouden nog zeven mensen met een coronabesmetting in het ziekenhuis liggen. Op het hoogtepunt van de coronacrisis lagen er dertig Covid-19 patiënten op de IC in Breda.
20.03
Militairen van de Generaal Majoor de Ruyter van Steveninckkazerne in Oirschot zijn mogelijk besmet met het coronavirus. 22 soldaten zitten thuis in quarantaine en wachten op de uitslag van de coronatest. Ze hebben klachten die bij het virus horen. Inmiddels zijn dertien andere militairen negatief getest op Covid-19. Toch heeft defensie uit voorzorg alle andere leden van de opleiding waar de mogelijk besmette militairen op zitten naar huis gestuurd. Iedereen is dus naar huis gestuurd en is niet op de kazerne zelf in quarantaine gegaan.
18.38
De genen bepalen mede hoe ziek iemand wordt
van het coronavirus. Bepaalde plekken in het DNA
kunnen ervoor zorgen dat mensen bevattelijker zijn voor het virus. Dit hebben onderzoekers van onder meer de Rijksuniversiteit Groningen en het Universitair Medisch Centrum Groningen ontdekt, zo meldt het ANP.
De onderzoekers deden mee aan een internationale studie, die ook in Italië en Spanje is uitgevoerd. De resultaten daarvan zijn donderdag verschenen in het wetenschapsblad New England Journal of Medicine. De ontdekking kan misschien helpen bij het vinden van een medicijn.
Voor het Groningse onderzoek Lifelines was al het DNA beschikbaar van tienduizenden noorderlingen. Zij vullen elke twee weken een vragenlijst over hun gezondheid in. De onderzoekers kunnen de antwoorden vergelijken met het genetisch materiaal om patronen te zoeken.
17.16
Eliška Slováková uit Eindhoven kroop achter haar naaimachine en heeft duizend mondkapjes gemaakt voor kwetsbare mensen en professionals in vitale beroepen. De van oorsprong Tsjechische designer verkocht mondmaskers via haar website en voor elk verkocht masker doneerde ze er drie.
De mondkapjes gingen naar verschillende vluchtelingencentra, dierenarts-, fysiotherapie- en verloskundigenpraktijken en organisaties als Zusters van Moeder Teresa en Ervaring die Staat.

15.54
Brabanders hebben een stuk vaker antistoffen tegen het coronavirus in hun bloed dan inwoners van andere provincies. Dit constateert bloedbank Sanquin uit een nadere analyse van de ruim 7000 bloedmonsters die tussen 9 en 18 mei zijn getest. In het midden
en het oosten van Brabant en in Limburg bleek tussen de 8 en 10
procent van de onderzochte monsters antistoffen te bevatten.
LEES MEER: Brabanders hebben stuk vaker antistoffen tegen coronavirus in bloed
14.53
In Brabant zijn er in totaal 9651 mensen besmet (geweest) met het virus, meldt het RIVM. Dat zijn er 14 meer dan woensdag. In de provincie zijn er in totaal 1531 sterfgevallen gemeld.
14.04
In de afgelopen 24 uur zijn er 132 nieuwe personen in het land positief getest op COVID-19. Dit meldt het RIVM. Drie mensen zijn vanwege het virus in het ziekenhuis opgenomen (geweest). Er zijn 4 sterfgevallen bijgekomen sinds woensdag. Het totaal aantal besmettingen is opgelopen tot 49.319. Het dodental staat inmiddels op 6078.
Grafiek van het aantal coronadoden:
13.12
De zingende zusjes van OG3NE gaan langzamerhand weer wat meer naar buiten. Ze stoppen daarom met hun 'Home Isolation Video's'. De laatste is donderdagmiddag online gezet.
LEES OOK: OG3NE supertrots dat Queen hun thuisisolatieversie van Bohemian Rhapsody heeft gedeeld
11.58
Het Muziekgebouw in Eindhoven kan met inachtneming van de coronavoorschriften de komende tijd 401 bezoekers toelaten in de grote zaal. Dat blijkt uit onderzoek van de Technische Universiteit Eindhoven, met wiskundige simulaties. Met twee voorstellingen per avond kan dan zeventig procent van de capaciteit worden benut zonder dat een stoel meer dan één keer op een avond wordt verkocht. Volgens directeur Wim Vringer van Muziekgebouw Eindhoven, biedt dit een goed perspectief op de toekomstige exploitatie van de concertzalen. “Dit geeft ons het volle vertrouwen om bezoekers weer veilig van onze concerten te laten genieten."
11.54
Door de coronacrisis maken minder mensen in
Nederland gebruik van langdurige zorg. Veel mensen zijn overleden en
het aantal nieuwe aanvragen is sterk gedaald. Het aantal mensen dat
langdurige zorg krijgt, is met 2465 gedaald ten opzichte van voor de
corona-uitbraak. Dat meldt de Nederlandse Zorgautoriteit.
11.53
Het aantal Nederlandse reizigers dat door de coronamaatregelen is gestrand in
Marokko en graag terug wil naar Nederland ligt nu op enkele
honderden. Dat zegt een woordvoerder van het Samenwerkingsverband
Marokkaanse Nederlanders (SMN) tegen het ANP.
Marokko deed in maart de grenzen dicht wegens het coronavirus.
Buitenlanders mochten aanvankelijk niet uit het land vertrekken. Pas
eind april begonnen de eerste repatriëringsvluchten weer.
10.48
Een persoon die de demonstratie op de Dam in
Amsterdam op 1 juni bijwoonde, is besmet met het coronavirus, bevestigt de GGD. Volgens
een woordvoerster had de betoger op het moment dat hij of zij bij
het protest was nog geen klachten en heeft die dus geen anderen kunnen
besmetten.
Ook is niet duidelijk of de bron van de besmetting op de Dam ligt. Dat de demonstrant het coronavirus heeft, kwam
naar voren in een bron- en contactonderzoek van een ander iemand.
10.18
Door de coronacrisis gaan het komende anderhalf jaar
bijna achtduizend bedrijven in Nederland failliet, inclusief eenmanszaken. Dat verwacht kredietverzekeraar Coface. Dat komt neer op een
stijging van het aantal bedrijfsfaillissementen met 36 procent, in vergelijking met de voorgaande periode van achttien maanden.
Coface stelt dat de versoepeling van de maatregelen tegen het coronavirus niet opweegt tegen de schadelijke impact van de
quarantainemaatregelen op de wereldwijde economische groei.
08.41
Hoewel automobilisten weer ouderwets veel
kilometers lijken te maken, blijven files grotendeels uit. Volgens
directeur Jorn de Vries van Flitsmeister, een veelgebruikte
verkeersapp, komt dit doordat mensen nu meer verspreid de weg op
gaan.
"Normaal ging iedereen tussen zeven en negen uur de weg op. Mensen die thuis
kunnen werken, beginnen thuis en stappen dan bijvoorbeeld om tien uur
in de auto omdat het toch prettig is om collega's of klanten
face-to-face te zien."
08.06
De meer dan twee miljoen mensen met een beperking of
chronische aandoening vormen een vergeten groep als het gaat om de
versoepelingen van de coronaregels. Dat vindt de belangenorganisatie
Ieder(in).
Veel chronisch zieken in risicogroepen sluiten zich op in huis,
laat de organisatie weten. En blinden, slechtzienden en mensen in een rolstoel kunnen zich niet
goed houden aan de gevraagde anderhalve meter afstand.
07.10
Het CDA en de ChristenUnie willen dat het kabinet negen miljoen euro uittrekt voor structurele steun aan voedselbanken. Dat
geld moet onder meer worden gebruikt voor wervingscampagnes om meer
vrijwilligers aan te trekken. Volgens de partijen is de rol van voedselbanken als gevolg van de
coronacrisis verder toegenomen. "Met de economisch zware tijden die
we tegemoet gaan, zullen meer mensen een beroep gaan doen op de
voedselbank", benadrukt CDA-Kamerlid Evert Jan Slootweg.
07.00
Om de 'kaalslag' op de arbeidsmarkt als gevolg van
de coronacrisis aan te pakken, is 750 miljoen euro extra nodig. Dat
geld moet worden gebruikt om mensen weer aan het werk te helpen. Dat kan deels door omscholing, maar ook door loopbaanbegeleiding. Dat
staat in het Deltaplan Werk van OVAL, branchevereniging voor
duurzame inzetbaarheid.
06.38
De werkloosheid in Nederland is, mede als gevolg
van de coronacrisis, opgelopen tot 3,6 procent van de
beroepsbevolking van 3,4 procent een maand eerder. Volgens het
Centraal Bureau voor de Statistiek (CBS) is het aantal mensen met
een betaalde baan sinds maart met 201.000 gedaald. Kenners hielden
in doorsnee rekening met een stijging van de werkloosheid tot 4,2
procent.
05.23
Het aantal WW-uitkeringen is in de drie maanden
dat de maatregelen tegen het coronavirus van kracht zijn met ruim
een kwart gestegen. Vooral jongeren met flexibel arbeidscontract
worden hard geraakt door de crisis, meldt uitkeringsinstantie UWV.
In totaal keerde de instantie in mei aan 301.000 mensen in Nederland
WW uit, terwijl dat er in februari nog 240.000 waren.
03.30
Afgevaardigden van alle clubs uit de eredivisie en
eerste divisie komen donderdagmiddag bijeen in Zeist voor een
algemene vergadering betaald voetbal. Ze praten onder meer over de
toekomst van de bedrijfstak na de uitbraak van het coronavirus.
03.30
Luchtvaartmaatschappij Transavia gaat vanaf
donderdag naar meer Europese bestemmingen vliegen. Sinds begin deze
maand vloog het bedrijf naar zes bestemmingen in Zuid-Europa, daar
komen er nu bijna tien bij. Tegelijkertijd gaat ook Flixbus weer
rijden in Nederland, voornamelijk naar België en Duitsland.
00.01
De armoede in Nederland zal in de toekomst met een
kwart toenemen als er geen andere maatregelen worden getroffen. Die
toename is waarschijnlijk nog groter als de gevolgen van de
coronacrisis duidelijk zijn, melden het Centraal Planbureau (CPB) en
het Sociaal en Cultureel Planbureau (SCP).